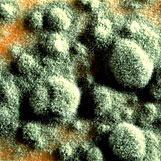
Mold Spores

MOLD REMOVAL & REMEDIATION
Our certified technicians have a vast amount of experience in mold removal and remediation and use up-to-date equipment and procedures to ensure proper containment of all materials. When removing mold from residential or commercial properties, we clean contaminated materials in a manner which prevents emissions of both fungal spores and dust that has been contaminated with fungi. We prevent it from escaping the project area and entering an occupied or non-abatement area. Our goal is to leave you with a mold free environment that is safe to breath, live and work in.
Alliance offers free mold inspections and testing. If you suspect or already have a mold problem, contact us to begin the remediation process so that your damages and health dangers do not continue to grow.
WHAT ARE MOLDS?
Molds are fungi that can be found both indoors and outdoors. No one knows how many species of fungi exist but estimates range from tens of thousands to perhaps three hundred thousand or more. Molds grow best in warm, damp, and humid conditions, and spread and reproduce by making spores. Mold spores can survive harsh environmental conditions, such as dry conditions, that do not support normal mold growth.
HOW DO MOLDS AFFECT PEOPLE?
Exposure to molds can cause symptoms such as nasal stuffiness, eye irritation, wheezing, or skin irritation. Some people, such as those with serious allergies to molds, may have more severe reactions. Severe reactions may occur among workers exposed to large amounts of molds in occupational settings, such as farmers working around moldy hay. Severe reactions may include fever and shortness of breath. Some people with chronic lung illnesses, such as obstructive lung disease, may develop mold infections in their lungs.
In 2004 the Institute of Medicine (IOM) found there was sufficient evidence to link indoor exposure to mold with upper respiratory tract symptoms, cough, and wheeze in otherwise healthy people; with asthma symptoms in people with asthma; and with hypersensitivity pneumonitis in individuals susceptible to that immune-mediated condition. The IOM also found limited or suggestive evidence linking indoor mold exposure and respiratory illness in otherwise healthy children.
Mold Spores
Mold Damage After Flooding
